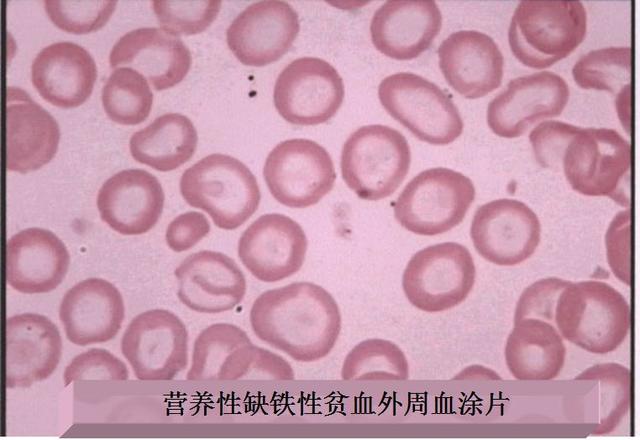
为什么缺铁性贫血那么多？那是没选对补铁食物。这3样补铁最好

铁是人体内含量至少的必须微量元素。所谓必需微量元素,等于指那些切切不克不及短少的元素,一旦缺乏,轻则抱病,重则小命不保。人体内笼统有4~5克铁,全数的铁都与蛋白质笼络,没有游离的铁离子,这是因为岂论是二价或三价的铁离子,对细胞都是有毒的。人体内的铁有两种具有内容:从命性铁和贮存铁。当效用性铁不足时,储存铁就会转化为屈从性铁。
- 坚守性铁是人体内铁的主要具有内容,其中血红蛋白中的铁占总铁量的60%~75%,肌红卵白占3%,1%为含铁酶类(细胞色素、细胞色素侵蚀酶、过侵蚀物酶、过腐蚀氢酶),这些铁弘扬着铁的生理苦守。
- 贮存铁以铁卵白和含铁血黄素模式具备于肝、脾与骨髓中,约占体内总铁的25%~40%。
一旦孕育发生缺铁,贮存铁首先劈头减少,展现为铁卵白低于畸形。要是不能及时补充,死守性铁就会降落。因为血红蛋白中的铁占了功用性铁的三分之二以上,受到缺铁的影响最大,以是缺铁后最思空见贯的即是缺铁性血虚。实践上,缺铁性贫血是最常见的血虚类型,也是环球到那时也没能希图的民众康健题目。
一样平常情况下血液中血红蛋白含量,出生6个月至6岁为110g/L以上, 6-14岁为120g/L,成人男性130g/L,女性为120g/L,孕妇为110g/L。低于这个标准等于血虚。缺铁是构成血虚的最首要缘故原由,尤其以婴幼儿、幼儿、妇女、孕妇、白叟多见。

可是在自然界,铁其实不是甚么罕有金属,几近全部的动动物傍边都有铁。大量调查研究也缔造,得多缺铁性贫血的人饮食当中的铁其实不少。那为啥还会产生缺铁性贫血呢?副本,人体对铁的排汇极为非凡。
人体对铁的排汇有两种纯粹一致的路径,也因此将食物当中的铁分为两大类,离别是血红素铁与非血红素铁。对血红素铁的吸引率相比高,在20~40%之间。而对非血红素铁的吸收则尤为低,只有1~5%。差别食品当中的铁含量差别宏壮。我们优先决定铁含量高何况以血红素铁为主的食品补铁,其次抉择铁含量比拟高可是依旧是以血红素铁为主的食物。至于所含铁为非血红素铁的食物,哪怕铁含量再高,也弗成能有效补铁。




